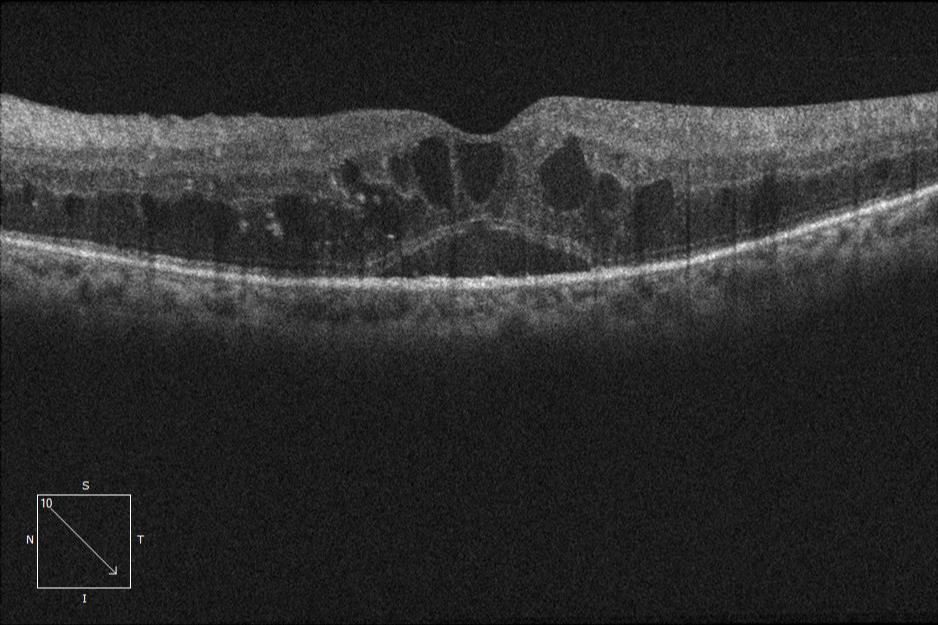

Indicaciones clínicas
👁️🗨️
- Edema macular diabético (EMD) con disminución visual.
- Retinopatía diabética proliferativa (RDP), solos o combinados con láser.
- Previo o posterior a vitrectomía, según el caso.
- No sustituye la fotocoagulación cuando existe isquemia periférica extensa.
- Pueden prevenir hemorragias vítreas en etapas proliferativas.

Última actualización: 2025-10-22 20:25:24